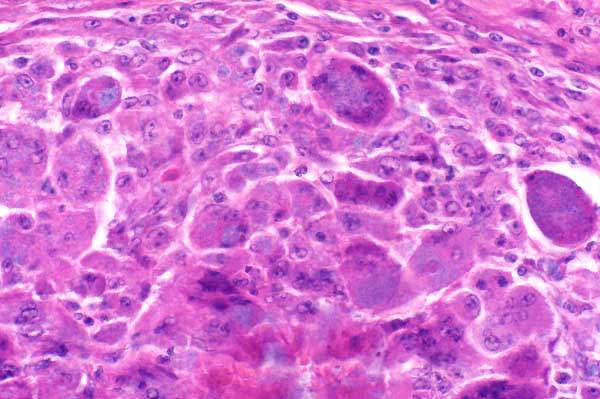

| 40x | Hematoxylin and Eosin | ||||
| Close Window | Macro View | Show Help | Back | |
|
Note the presence of numerous basophilic bacilli within the cytoplasm of multinucleated giant cells and in the necrotic debris.
|
||||

|
||||
| Return | ||||
|
Note the presence of numerous basophilic bacilli within the cytoplasm of multinucleated giant cells and in the necrotic debris.
|
||||